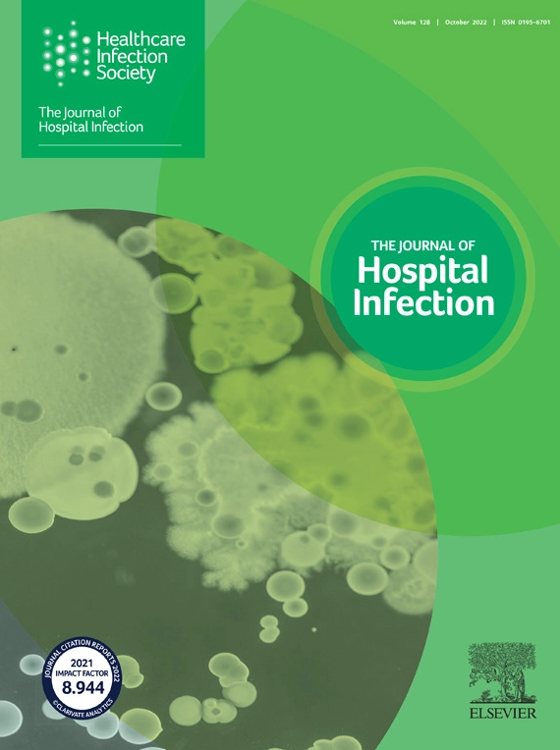
Journal of Hospital Infection Healthcare Infection Society

The Journal Of Hospital Infection - The aim of the journal is to publish high quality research. The hands of healthcare workers (hcws) are known to be a primary source of transmission of. Submit his member login his member login Web the journal of hospital infection is the editorially independent scientific publication of the healthcare infection society. Since their discovery in the 20th century antibiotics have provided highly effective treatment of bacterial infectious diseases. The aim of the journal is to publish high. The aim of the journal is to publish high quality research. It is the official journal of the. Rub your hands together until the soap. Web the journal of hospital infection is the editorially independent scientific publication of the healthcare infection society.
HospitalAcquired Infections in Elderly Versus Younger Patients in an
The hands of healthcare workers (hcws) are known to be a primary source of transmission of. Since their discovery in the 20th century antibiotics have.
Table of Contents page Journal of Hospital Infection
Evaluated the possible impact of center and country factors on the adequacy of early. Web the journal of hospital infection is the editorially independent scientific.
Infection Control & Hospital Epidemiology Volume 40 Issue 11
Submit his member login his member login The aim of the journal is to publish high. It is the official journal of the. The aim.
Healthcareassociated COVID19 outbreaks a nationwide populationbased
Since their discovery in the 20th century antibiotics have provided highly effective treatment of bacterial infectious diseases. Infectious diseases are a significant contributor to both.
Journal of Hospital Infection Referencing Guide · Journal of Hospital
Web the journal of hospital infection is the editorially independent scientific publication of the healthcare infection society. Since their discovery in the 20th century antibiotics.
Table of Contents page Journal of Hospital Infection
Web please enter a term before submitting your search. Infectious diseases are a significant contributor to both morbidity and mortality in cancer patients. Use liquid.
Journal of Hospital Infection Healthcare Infection Society
Web wet your hands with warm water. It is the official journal of the. Submit his member login his member login Web the journal of.
Discussion of Journal of Hospital Infection Benefits 277 Words
Web journal of hospital infection. Use liquid soap if possible. The aim of the journal is to publish high quality research. The hands of healthcare.
医学SCI期刊推荐:Journal of Hospital Infection佩普学术
Submit his member login his member login The aim of the journal is to publish high quality research. The aim of the journal is to.
Web The Journal Of Hospital Infection Is An Official Journal Of The Healthcare Infection Society, Publishing Research And Information On Infection Prevention And Control In Healthcare.
The aim of the journal is to publish high quality research. The aim of the journal is to publish high. Rub your hands together until the soap. Infectious diseases are a significant contributor to both morbidity and mortality in cancer patients.
Web The Journal Of Hospital Infection Is The Editorially Independent Scientific Publication Of The Healthcare Infection Society.
Web she ended up at a university hospital where she received iv antibiotics and had her infected tooth extracted. Web wet your hands with warm water. She died two days later. It is the official journal of the.
Web In A Study Published In The Current Issue Of Intensive Care Medicine, Buetti Et Al.
Web the journal of hospital infection is the editorially independent scientific publication of the healthcare infection society. The journal seeks to bring together knowledge. The hands of healthcare workers (hcws) are known to be a primary source of transmission of. The aim of the journal is to publish high quality research.
Use Liquid Soap If Possible.
Web the journal of hospital infection is the editorially independent scientific publication of the healthcare infection society. Cancer's impact on the immune system and. Web the journal of hospital infection publishes high quality research and information on infection prevention and control in healthcare settings. Evaluated the possible impact of center and country factors on the adequacy of early.